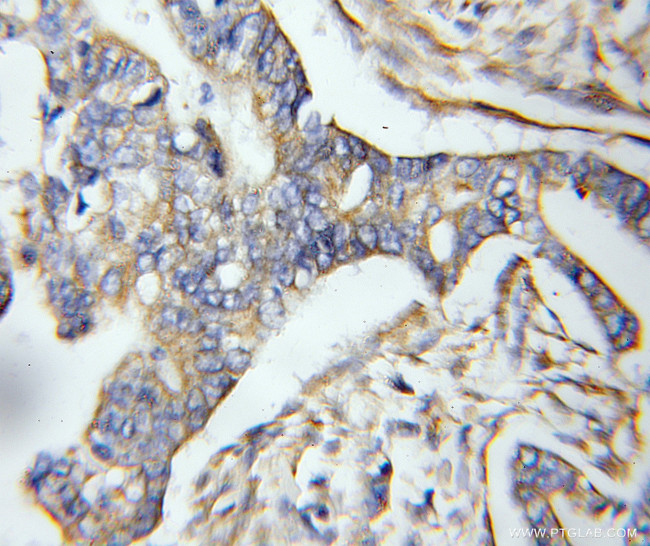
GPSM2 Antibody in Immunohistochemistry (Paraffin) (IHC (P))

Search
Proteintech
GPSM2 Polyclonal Antibody
{{$productOrderCtrl.translations['antibody.pdp.commerceCard.promotion.promotions']}}
{{$productOrderCtrl.translations['antibody.pdp.commerceCard.promotion.viewpromo']}}
{{$productOrderCtrl.translations['antibody.pdp.commerceCard.promotion.promocode']}}: {{promo.promoCode}} {{promo.promoTitle}} {{promo.promoDescription}}. {{$productOrderCtrl.translations['antibody.pdp.commerceCard.promotion.learnmore']}}
产品信息
11608-2-AP
已发表种属
宿主/亚型
分类
类型
抗原
偶联物
形式
浓度
规格
保存条件
运输条件
靶标信息
The protein encoded by this gene belongs to a family of proteins that modulate activation of G proteins, which transduce extracellular signals received by cell surface receptors into integrated cellular responses. The N-terminal half of this protein contains 10 copies of leu-gly-asn repeat, and the C-terminal half contains 4 GoLoco motifs, which are involved in guanine nucleotide exchange. This protein may play a role in neuroblast division and in the development of normal hearing. Mutations in this gene are associated with autosomal recessive nonsyndromic deafness.
仅用于科研。不用于诊断过程。未经明确授权不得转售。